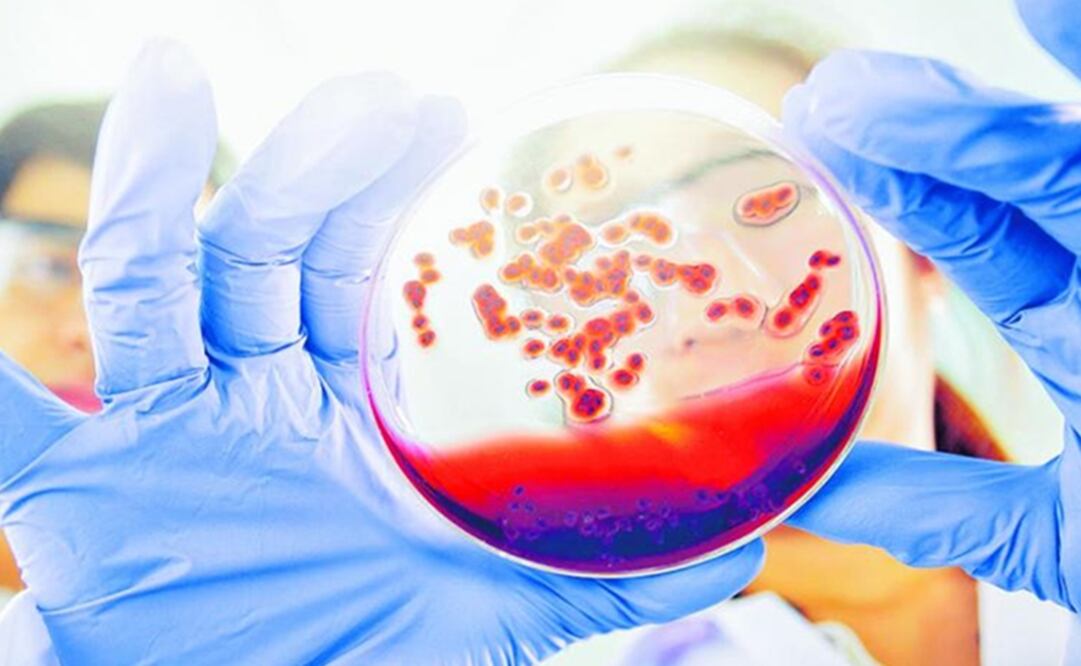
Foto: Especial

[Publicidad]
La Secretaría Departamental de Salud del Valle, Colombia , alertó a padres de familia sobre un supuesto reto viral que circula en redes sociales. Según la denuncia de esa dependencia, jóvenes están siendo llamados a tener relaciones sexuales con personas que padezcan VIH/Sida.
“Unos padres de familia llamaron para informarme que estaba circulando a través de internet una invitación de personas que tienen VIH/Sida a tener contacto sexual con ellos. Se ubican en la ciudad, envían el transporte y les garantizan una pastilla del día después , con la advertencia de que se va a jugar un reto, pero que existe una posibilidad de que la enfermedad no se transmita”, explicó María Cristina Lesmes , secretaria departamental de salud.
Sí existe una píldora para evitar el contagio entre personas que tienen el virus, pero requiere días de toma y no es tan sencillo como tomársela el día después de un contacto sexual con una de estas personas, añadió Lesmes , ya que el riesgo de contagio continúa siendo alto.
También la funcionaria añadió que han encontrado en aumento el número de personas con VIH/Sida , especialmente en menores de 14 años y, asegura, se está poniendo en riesgo la vida de muchos niños y adolescentes que se encuentran con estas tendencias peligrosas en redes sociales.
“Nos están poniendo en riesgo la vida de los niños, adicionalmente, y no necesariamente como una causa efecto, hemos encontrado que el número de personas con VIH/Sida ha aumentado en el último periodo de tiempo, especialmente en los niños menores de 14 años, es decir, que tenemos un resurgimiento de esta infección que si bien hoy no es una enfermedad mortal, sino una enfermedad crónica, con el tiempo afecta la vida de las personas y limitará su existencia de muchas formas”, insistió María Cristina Lesmes.
La Secretaria Departamental de Salud les recordó a los padres de familia que dentro de las responsabilidades del cuidado de los menores se encuentra la revisión de las redes sociales y la identificación de las personas con las que los jóvenes se relacionan.
[Publicidad]
agv
[Publicidad]
Más información

Universal Deportes
Mundial 2026: Brasil 3-0 Haití EN VIVO Sigue aquí el MINUTO A MINUTO del partido

Mundo
Incendio destruye histórica iglesia de 174 años en Brooklyn; no reportan heridos

Nación
Con bono pendiente, sección 7 de la CNTE evalúa si levanta plantón de la CDMX; debe esperar decisión de Asamblea Nacional

Metrópoli
Línea 7 del Metrobús modificará su servicio este sábado 20 de junio por evento deportivo; conoce las estaciones afectadas


Deportes
Partidos del Mundial 2026 en el Día del Padre: Horarios del 20 y 21 de junio y dónde ver EN VIVO

Deportes
Estados Unidos sigue imparable en el Mundial 2026: vence a Australia y ya está en dieciseisavos

Noticias
Revelan los sucios hábitos de Donald Trump que habrían enfurecido a Melania y tensado su matrimonio

Noticias
Alerta hoy por lluvias fuertes en CDMX y Edomex: advierten riesgo de inundaciones y granizo